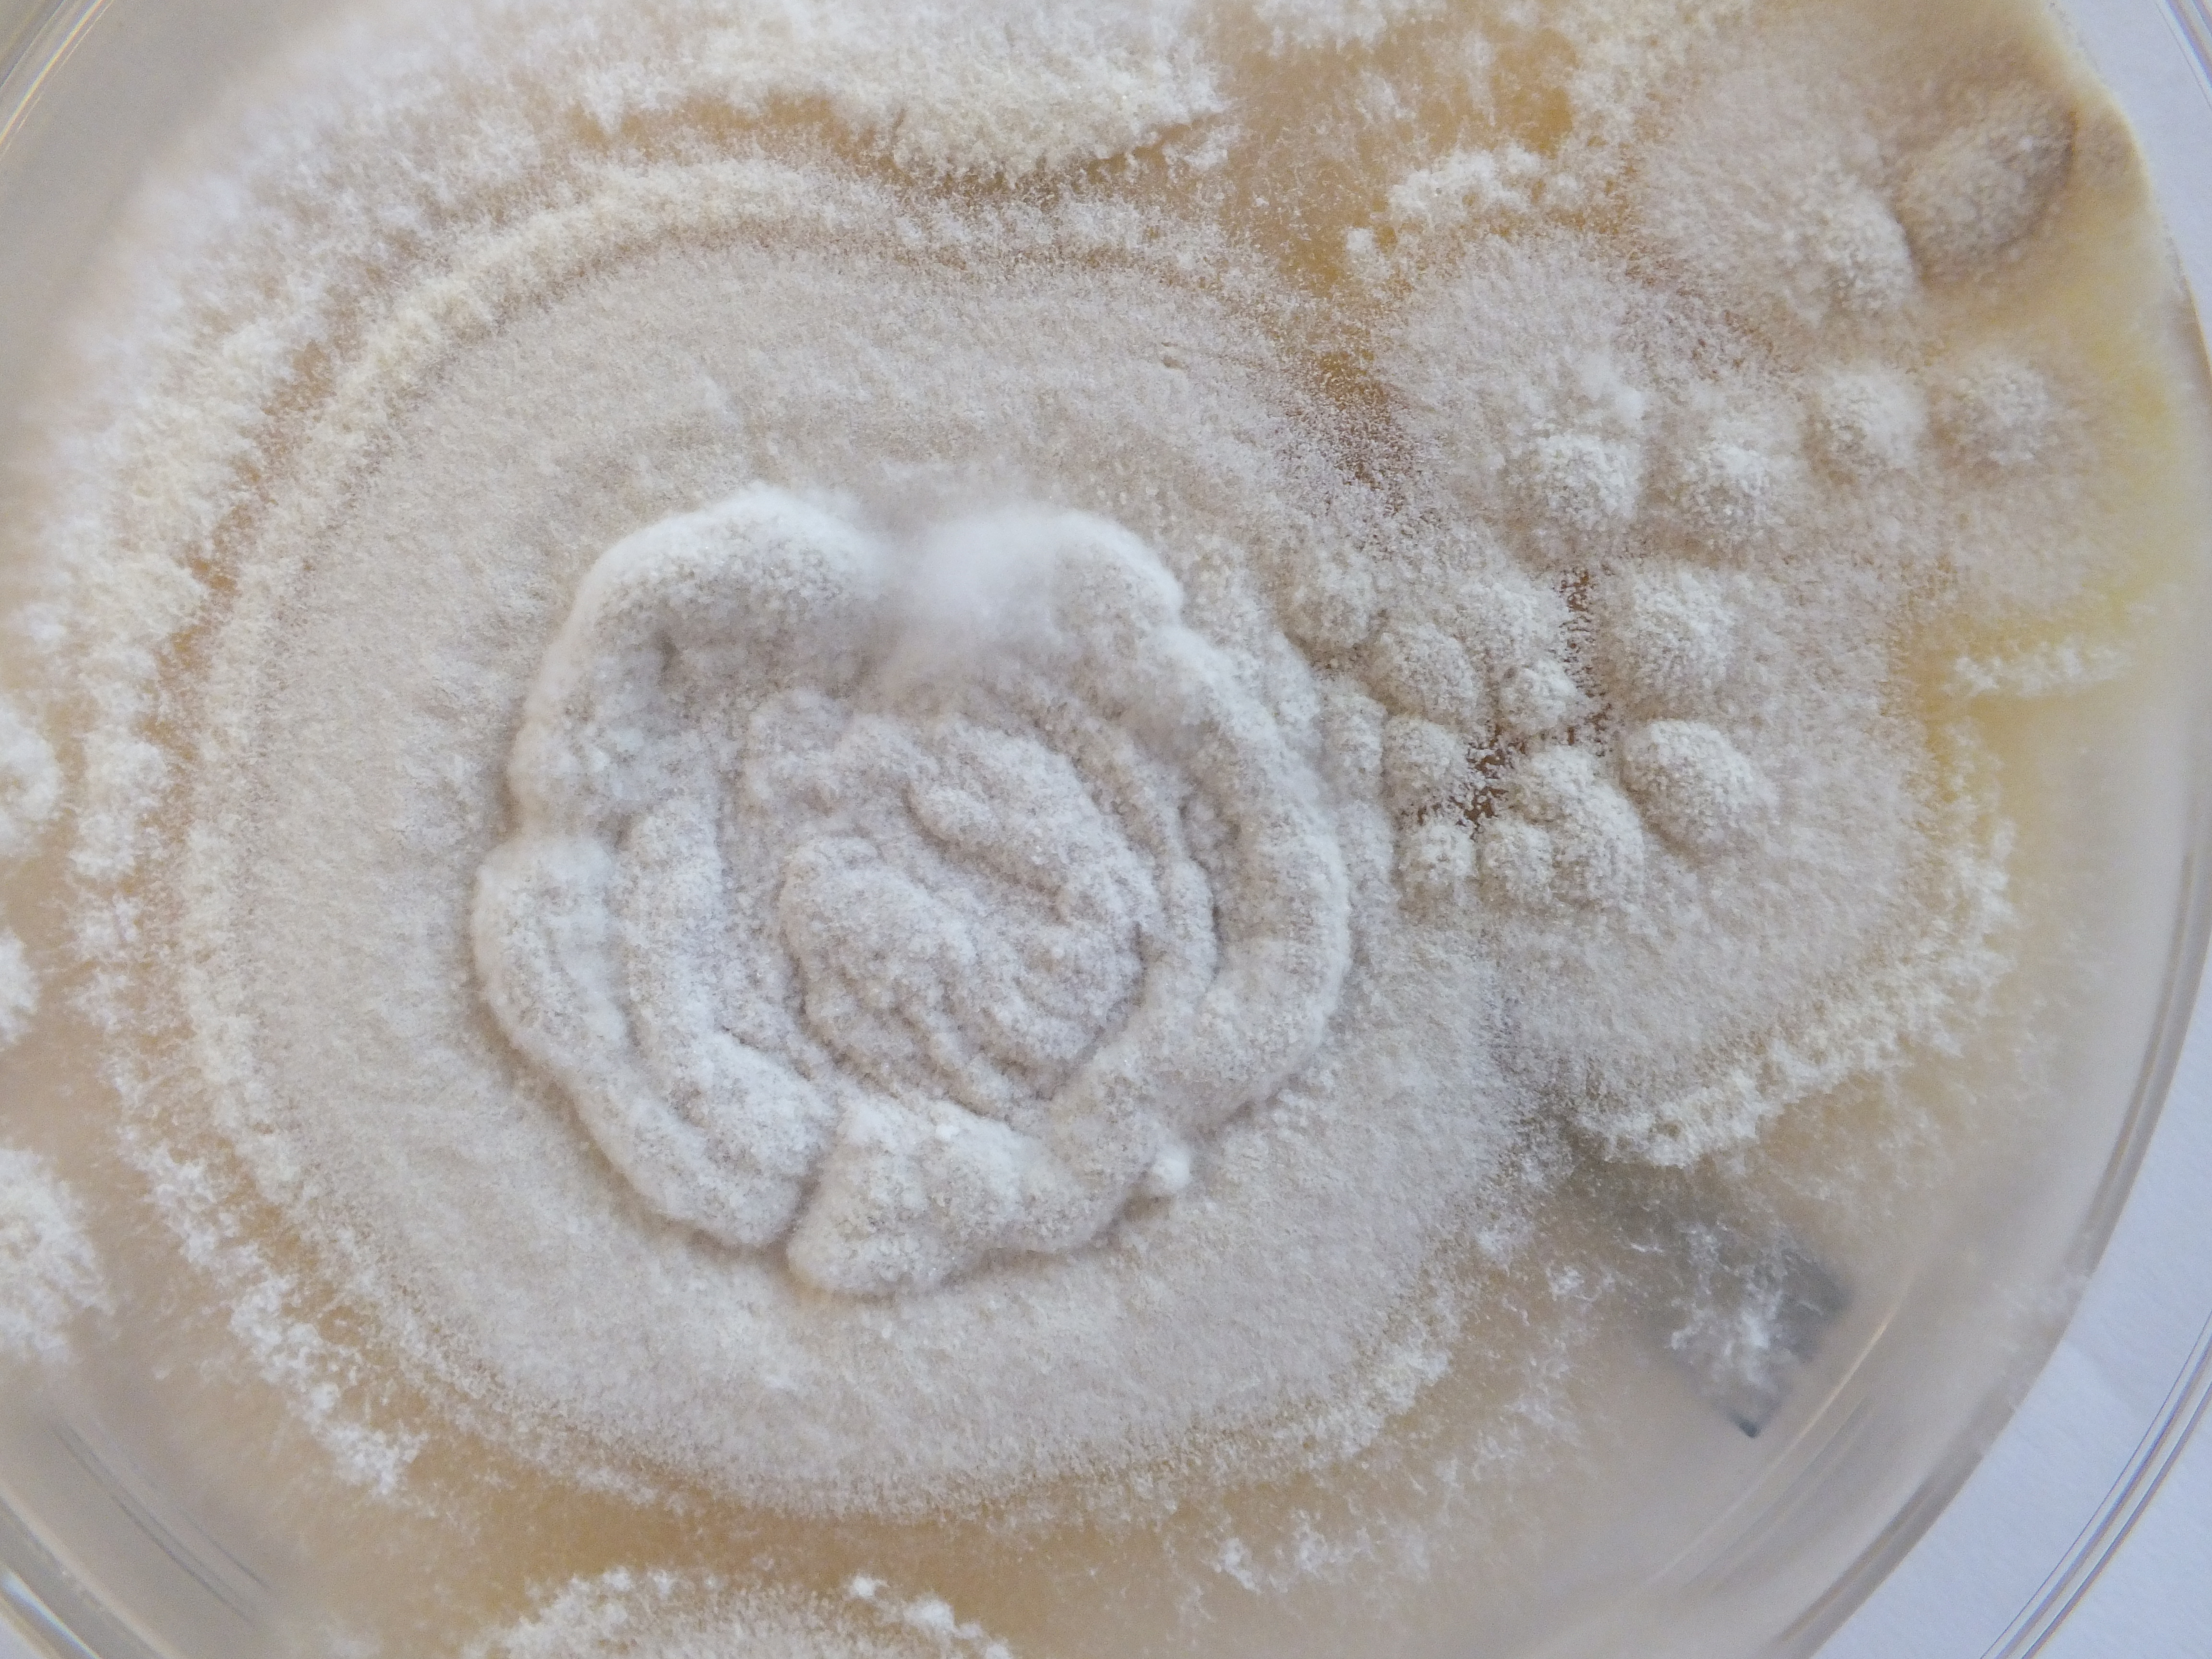
None
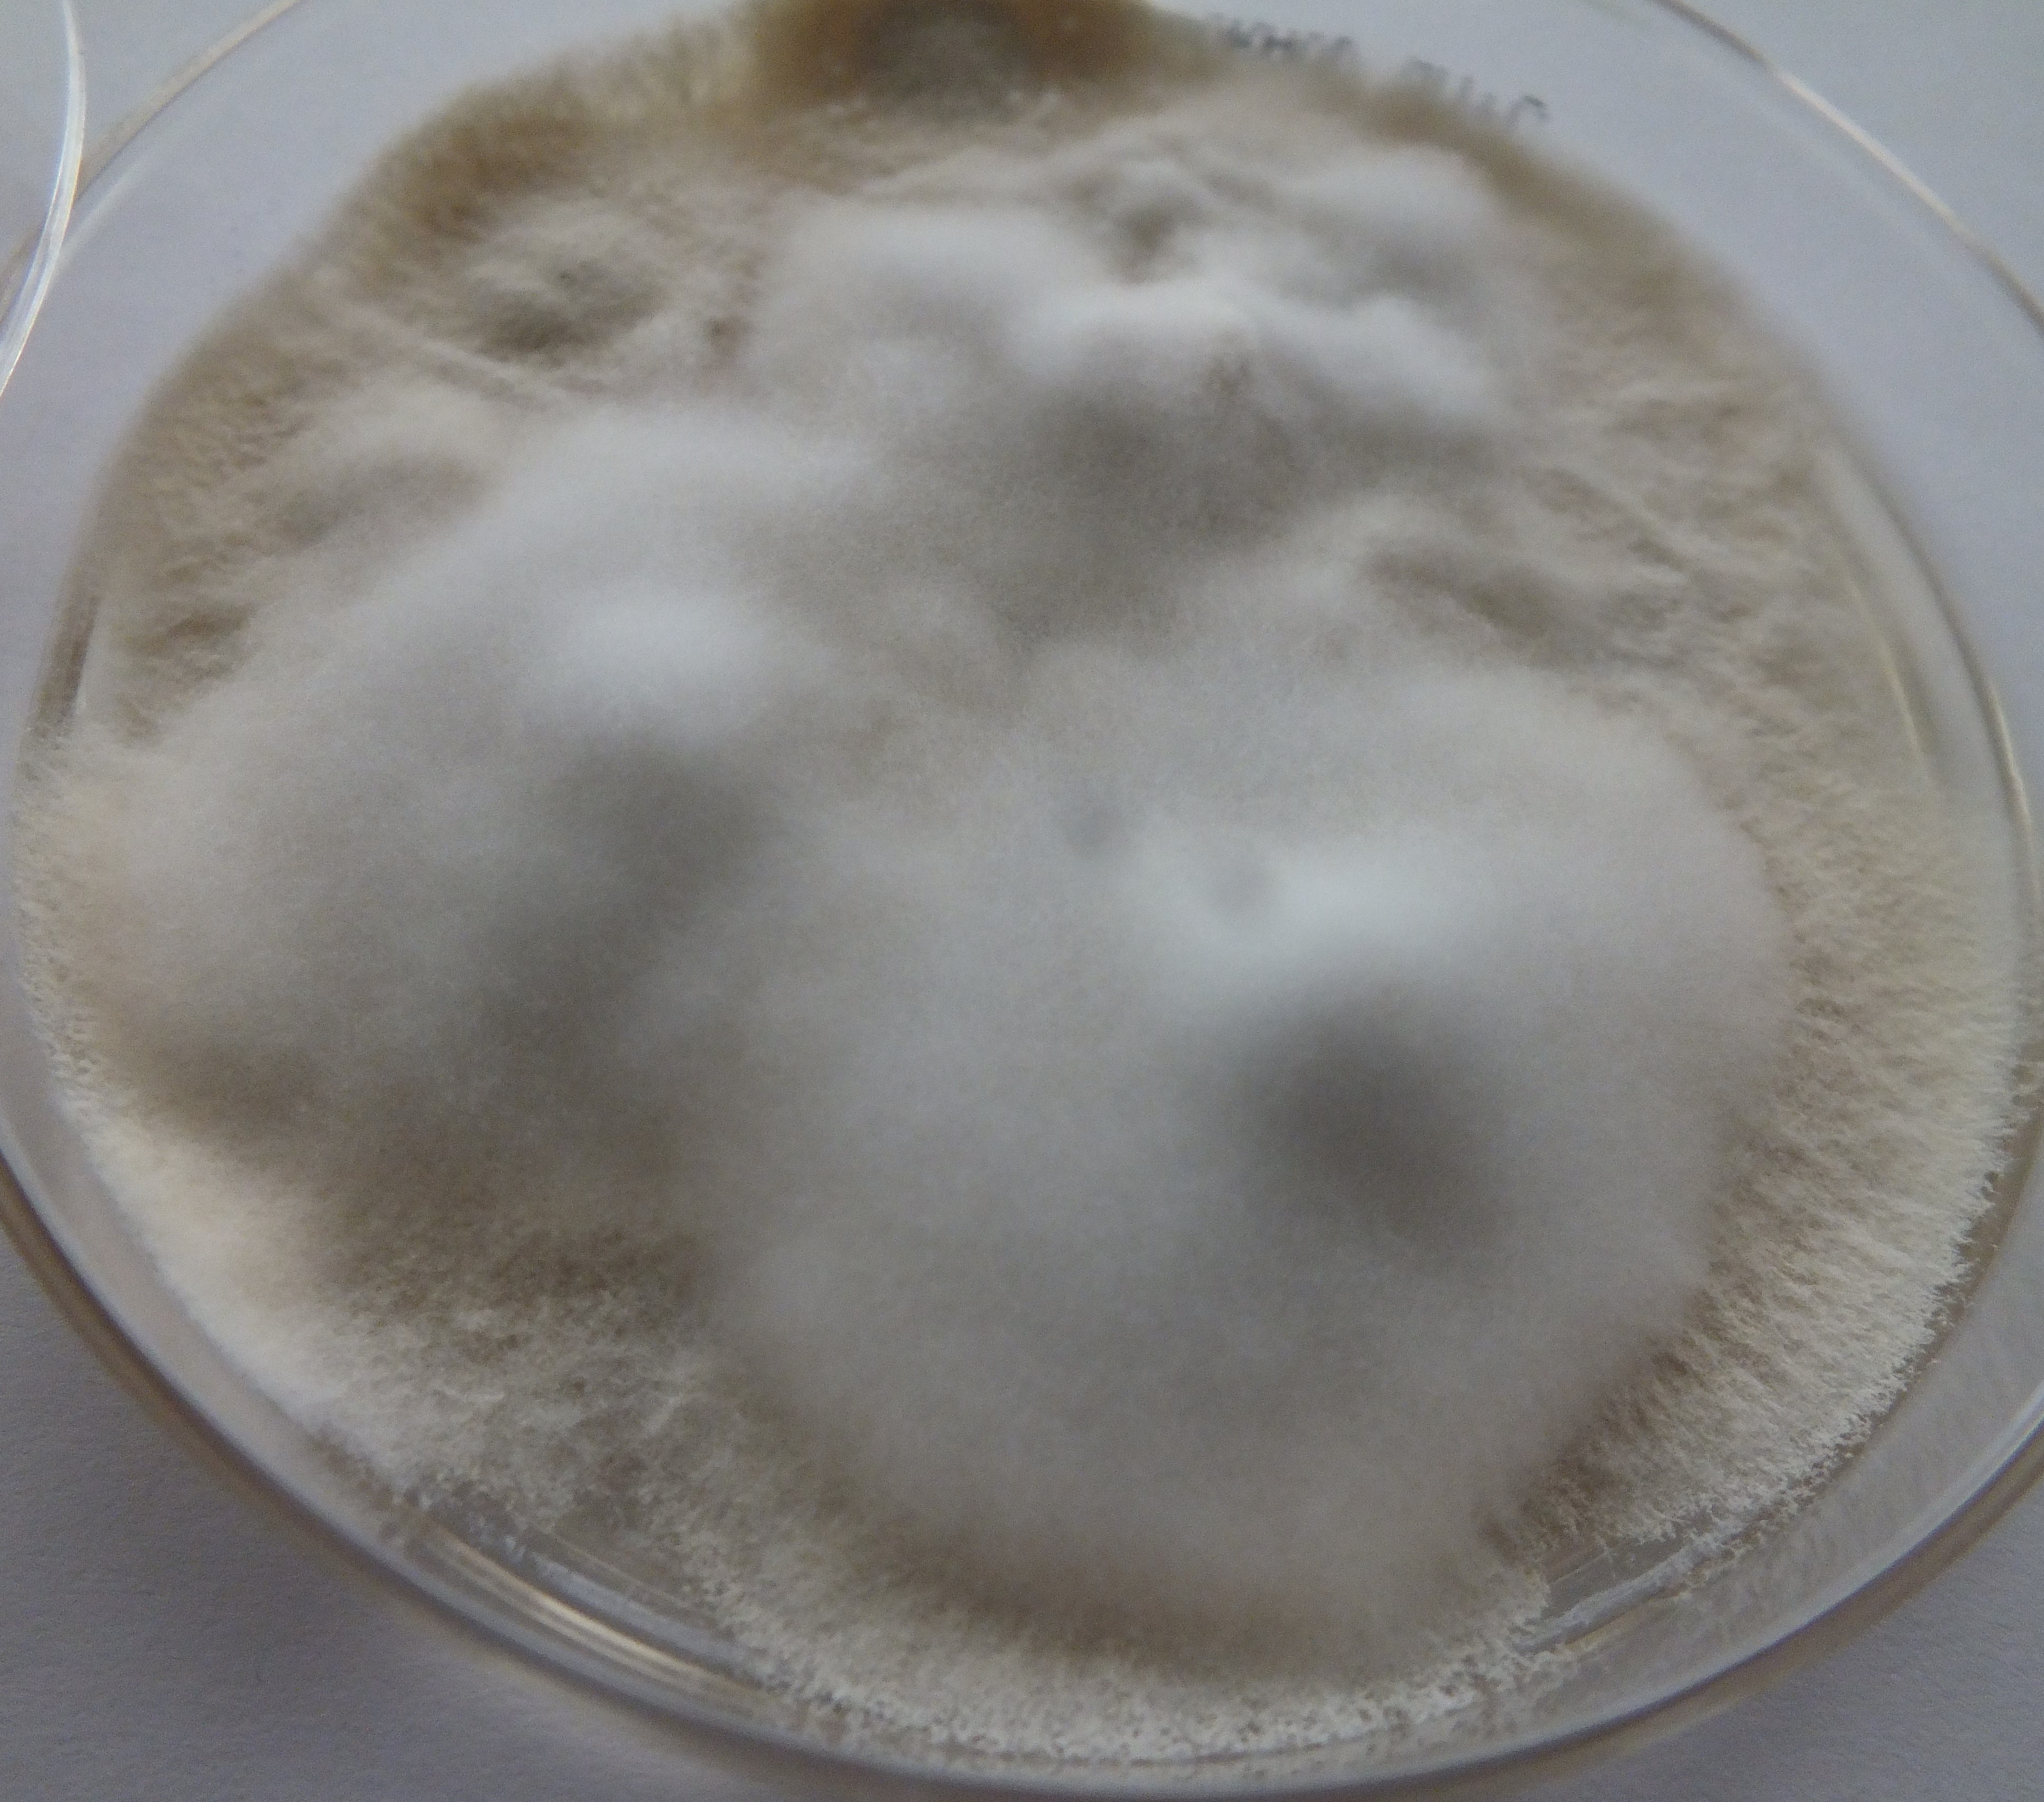
None
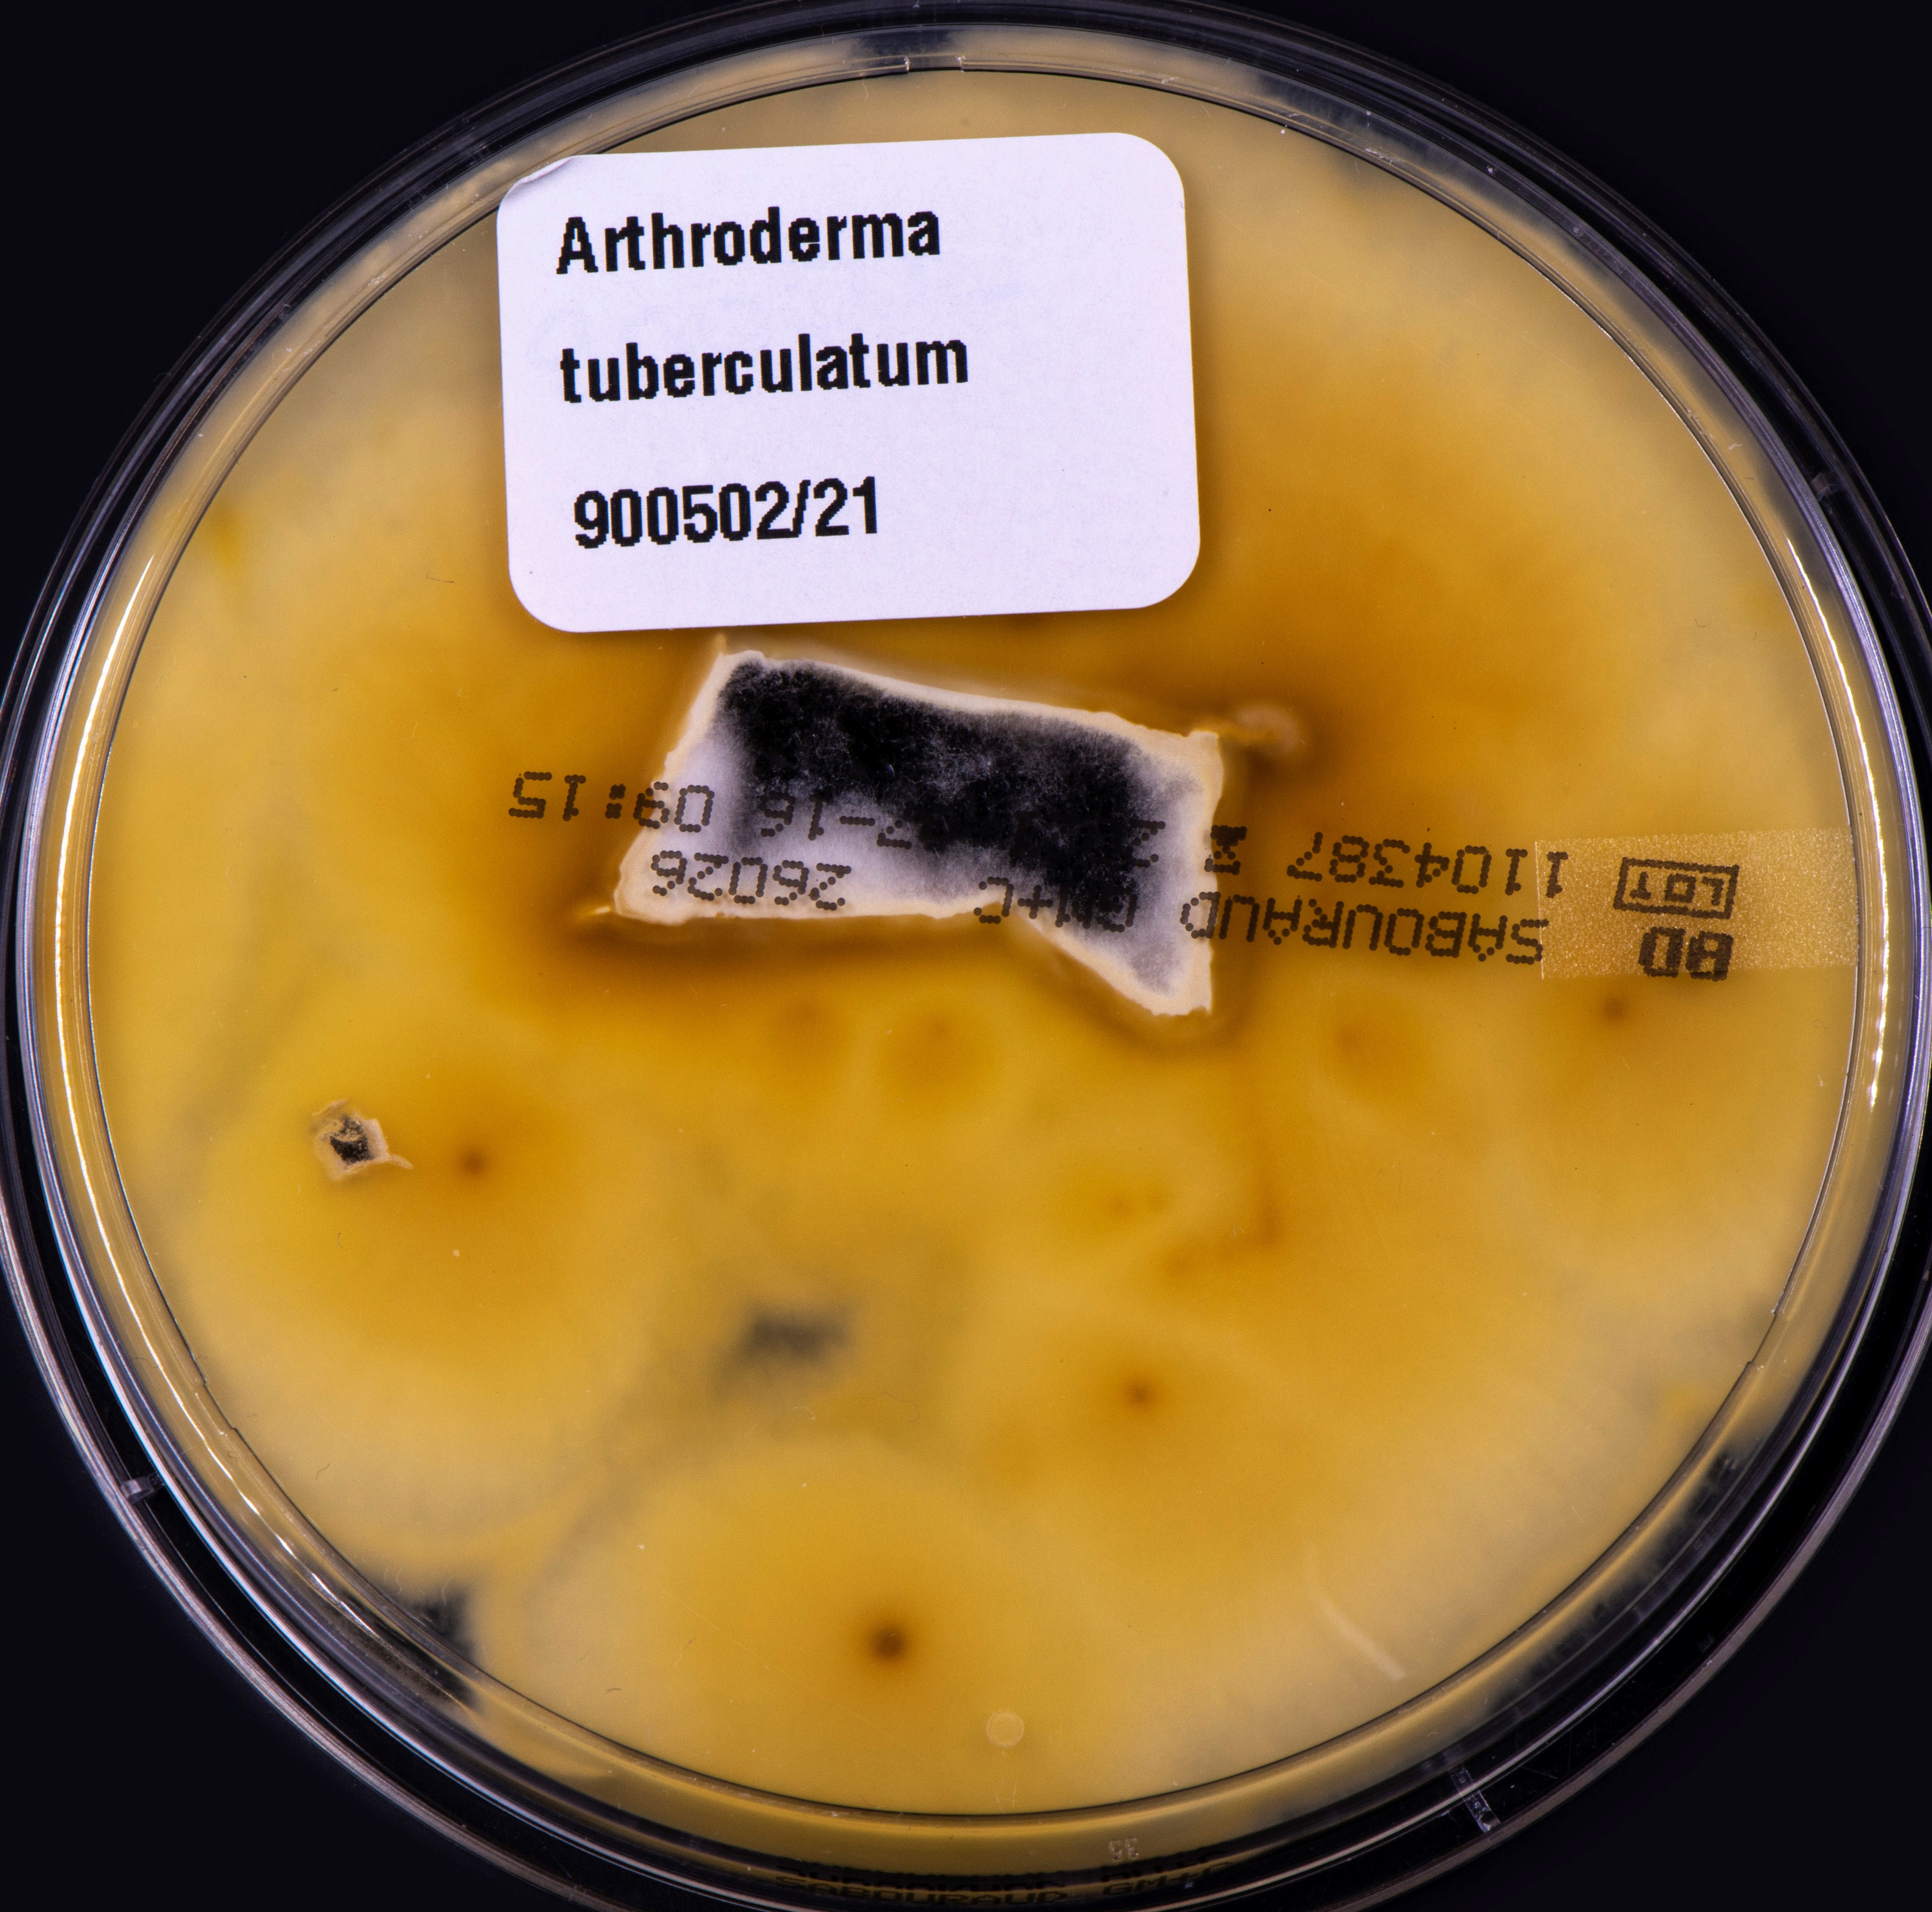
None
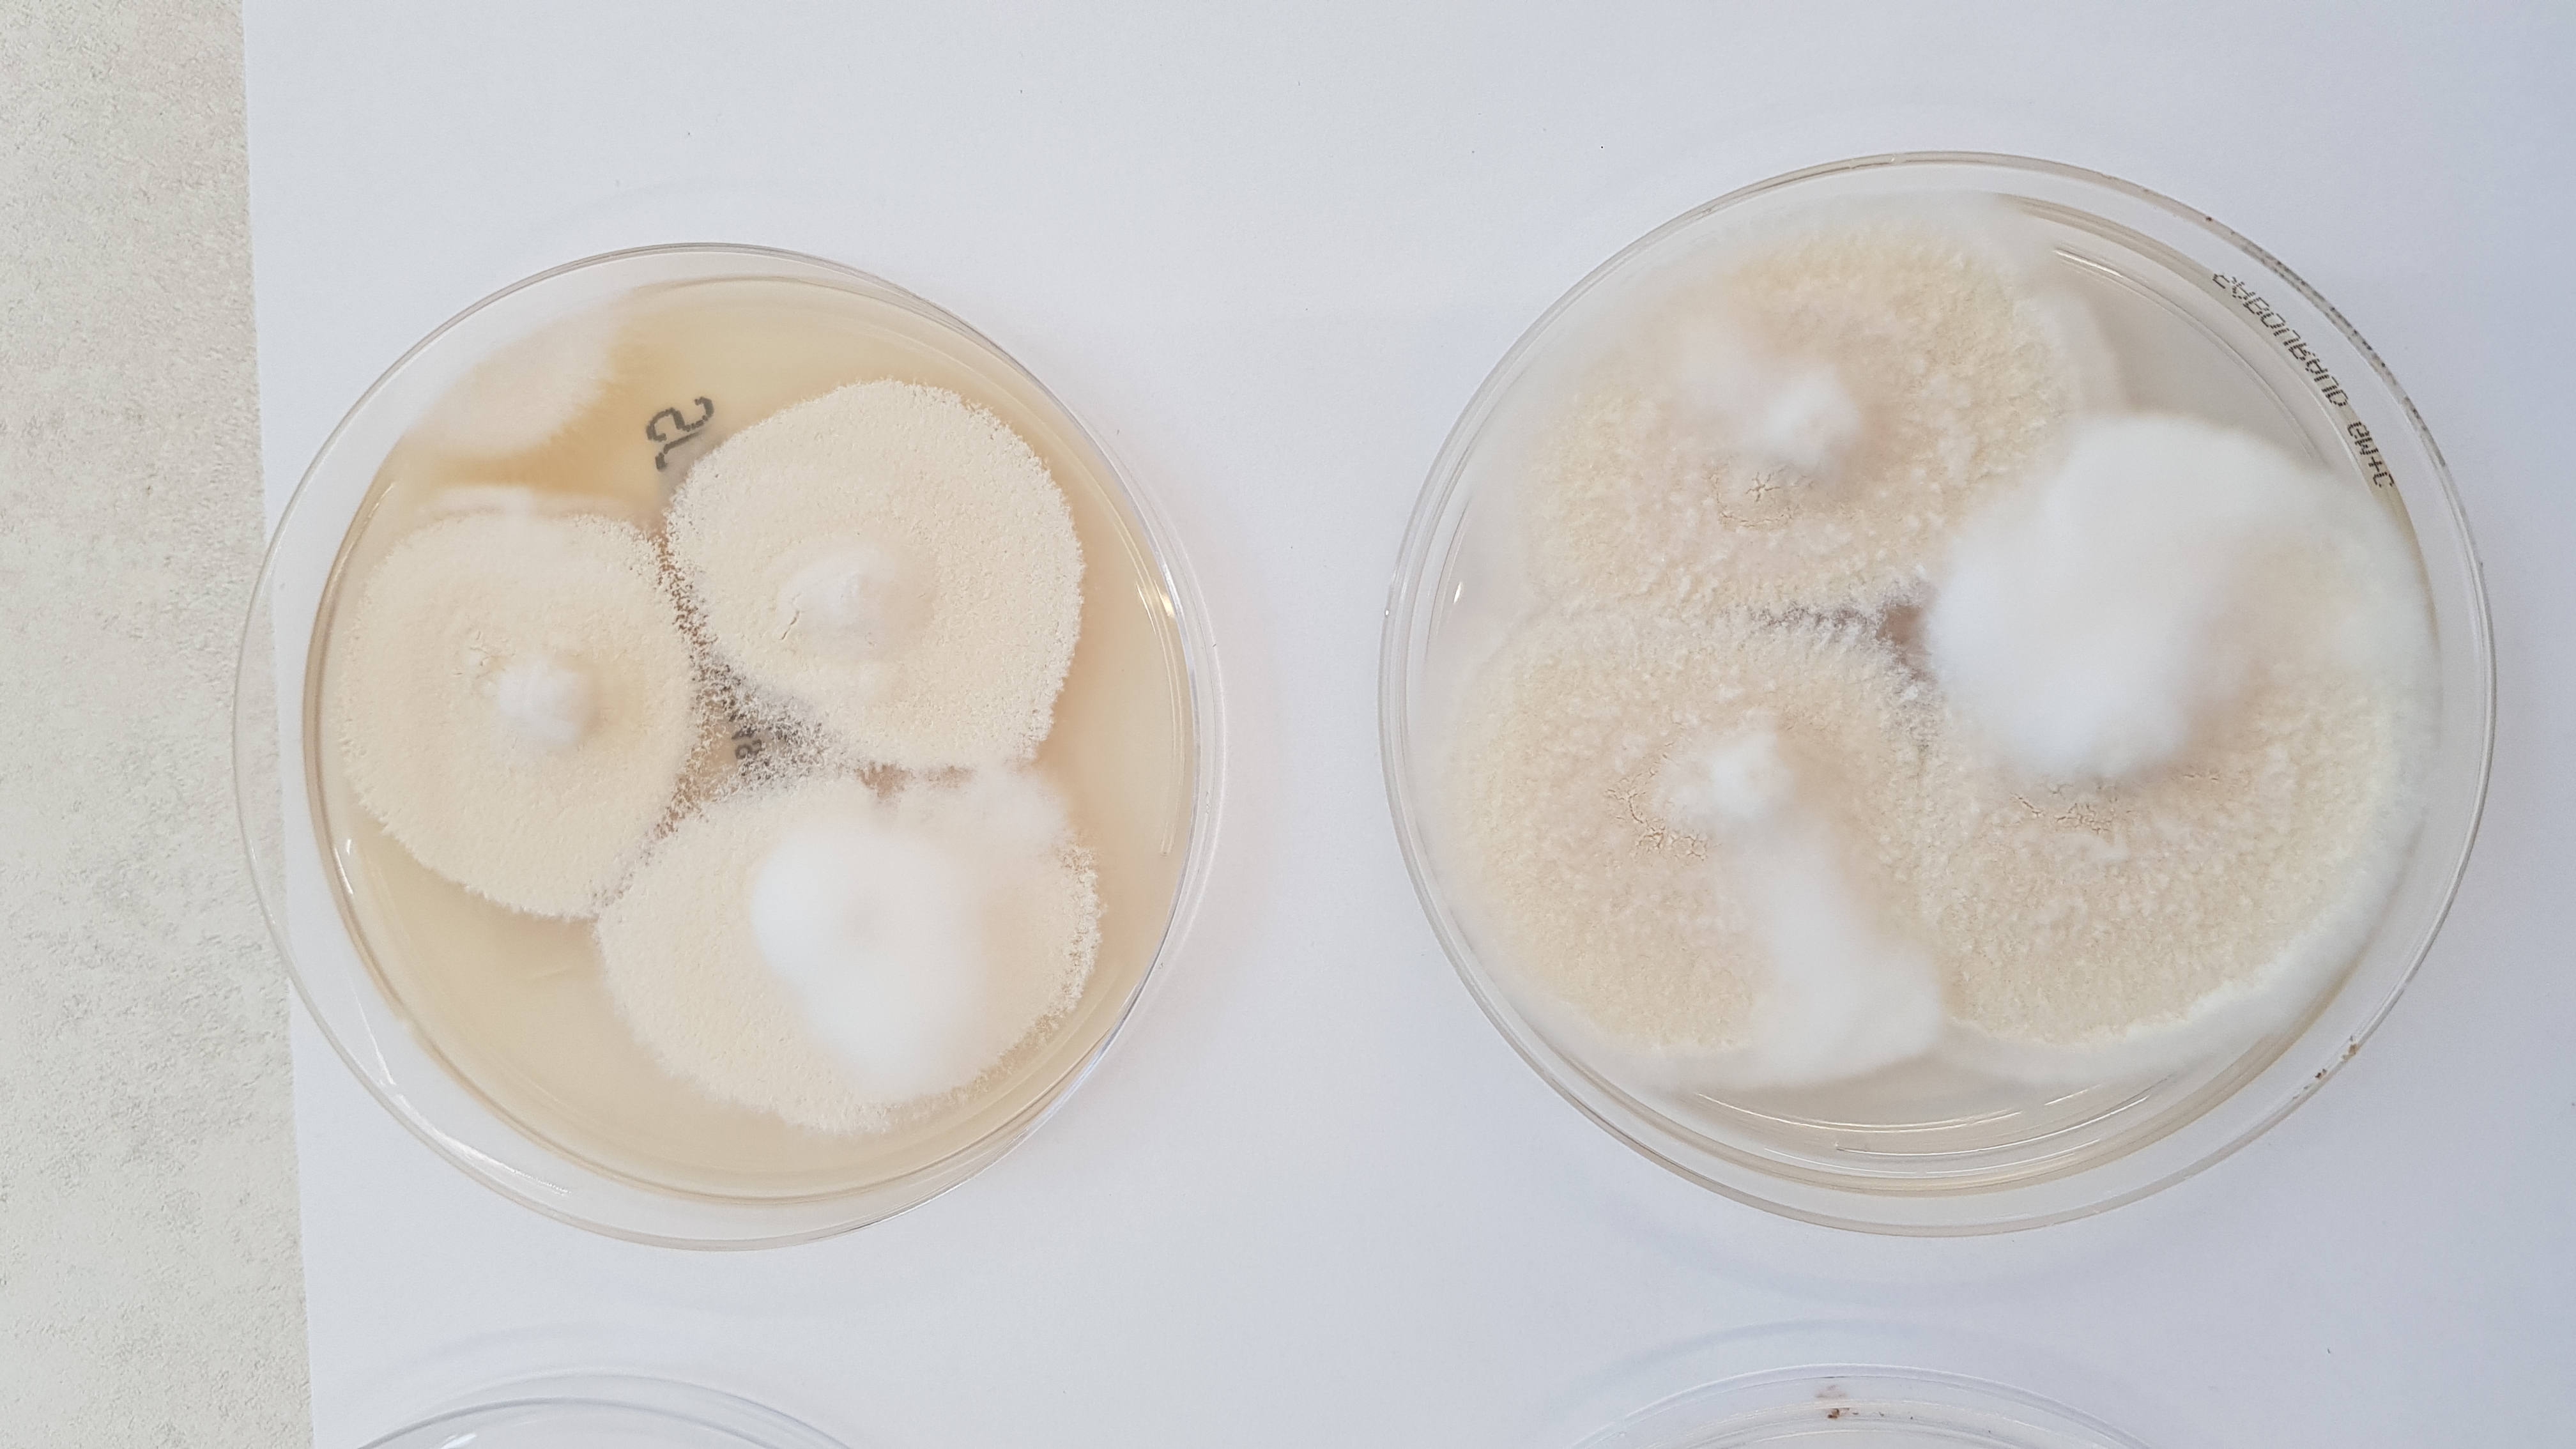
None
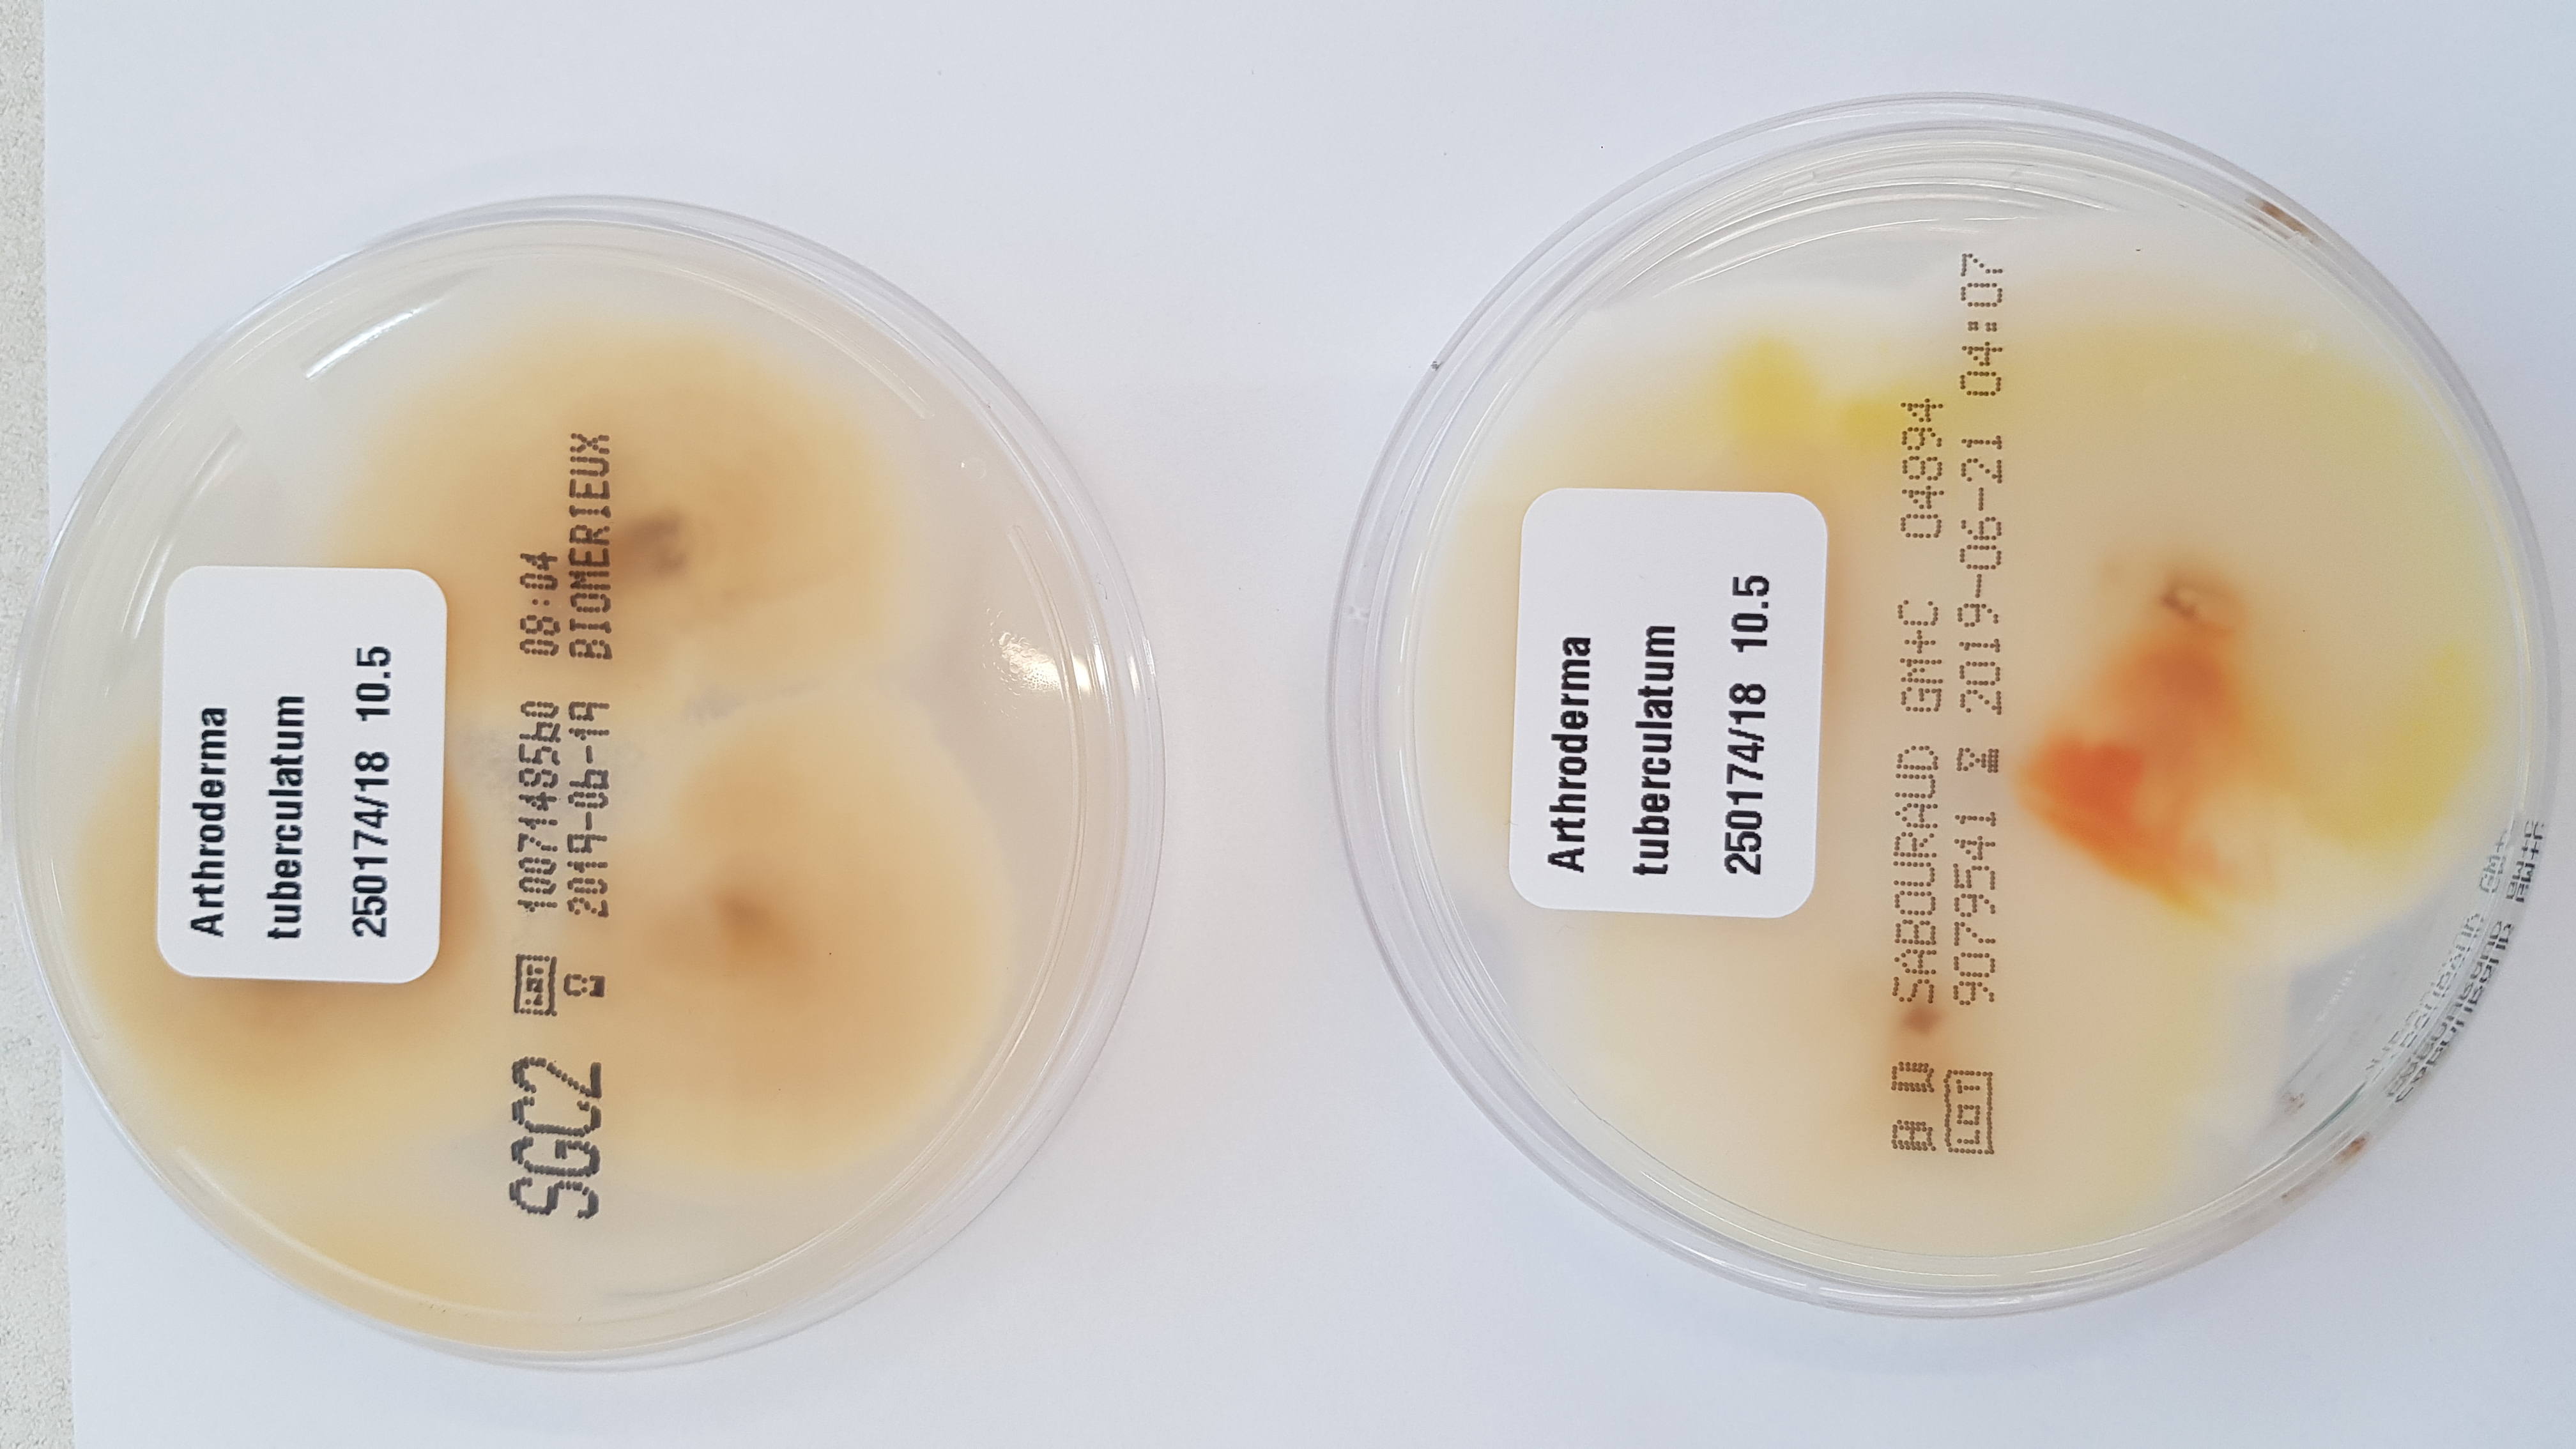
None
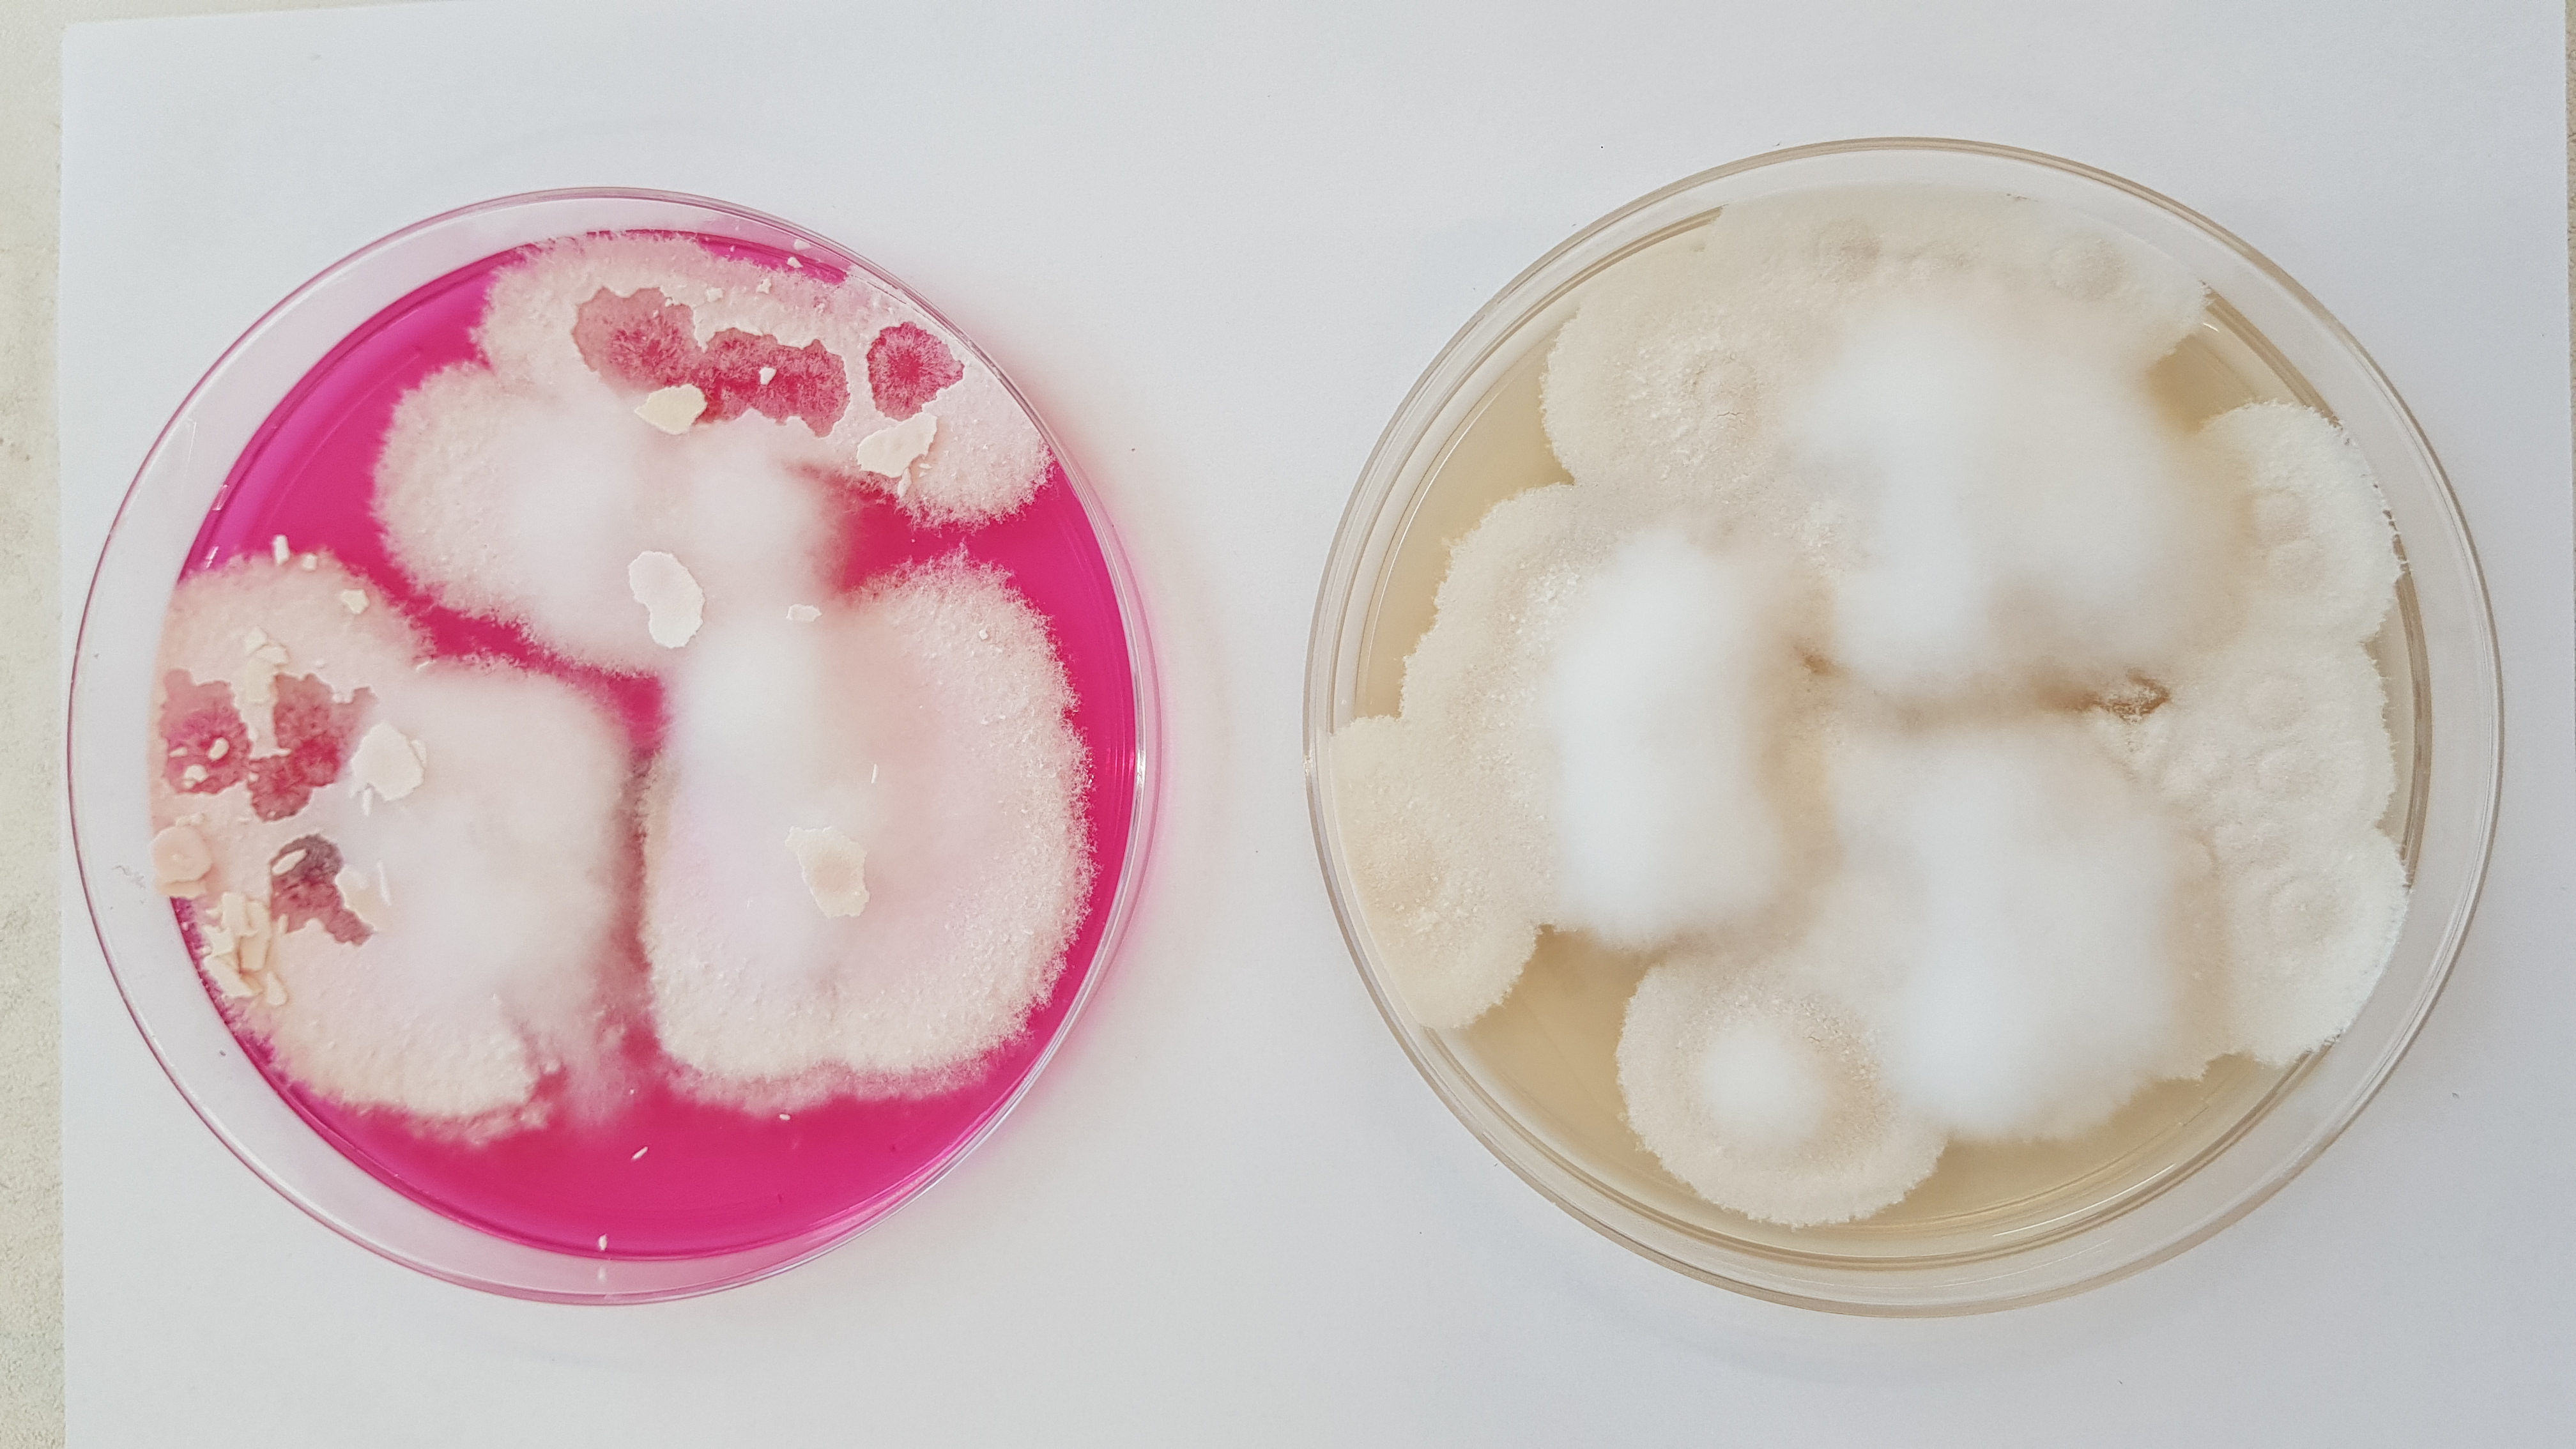
None
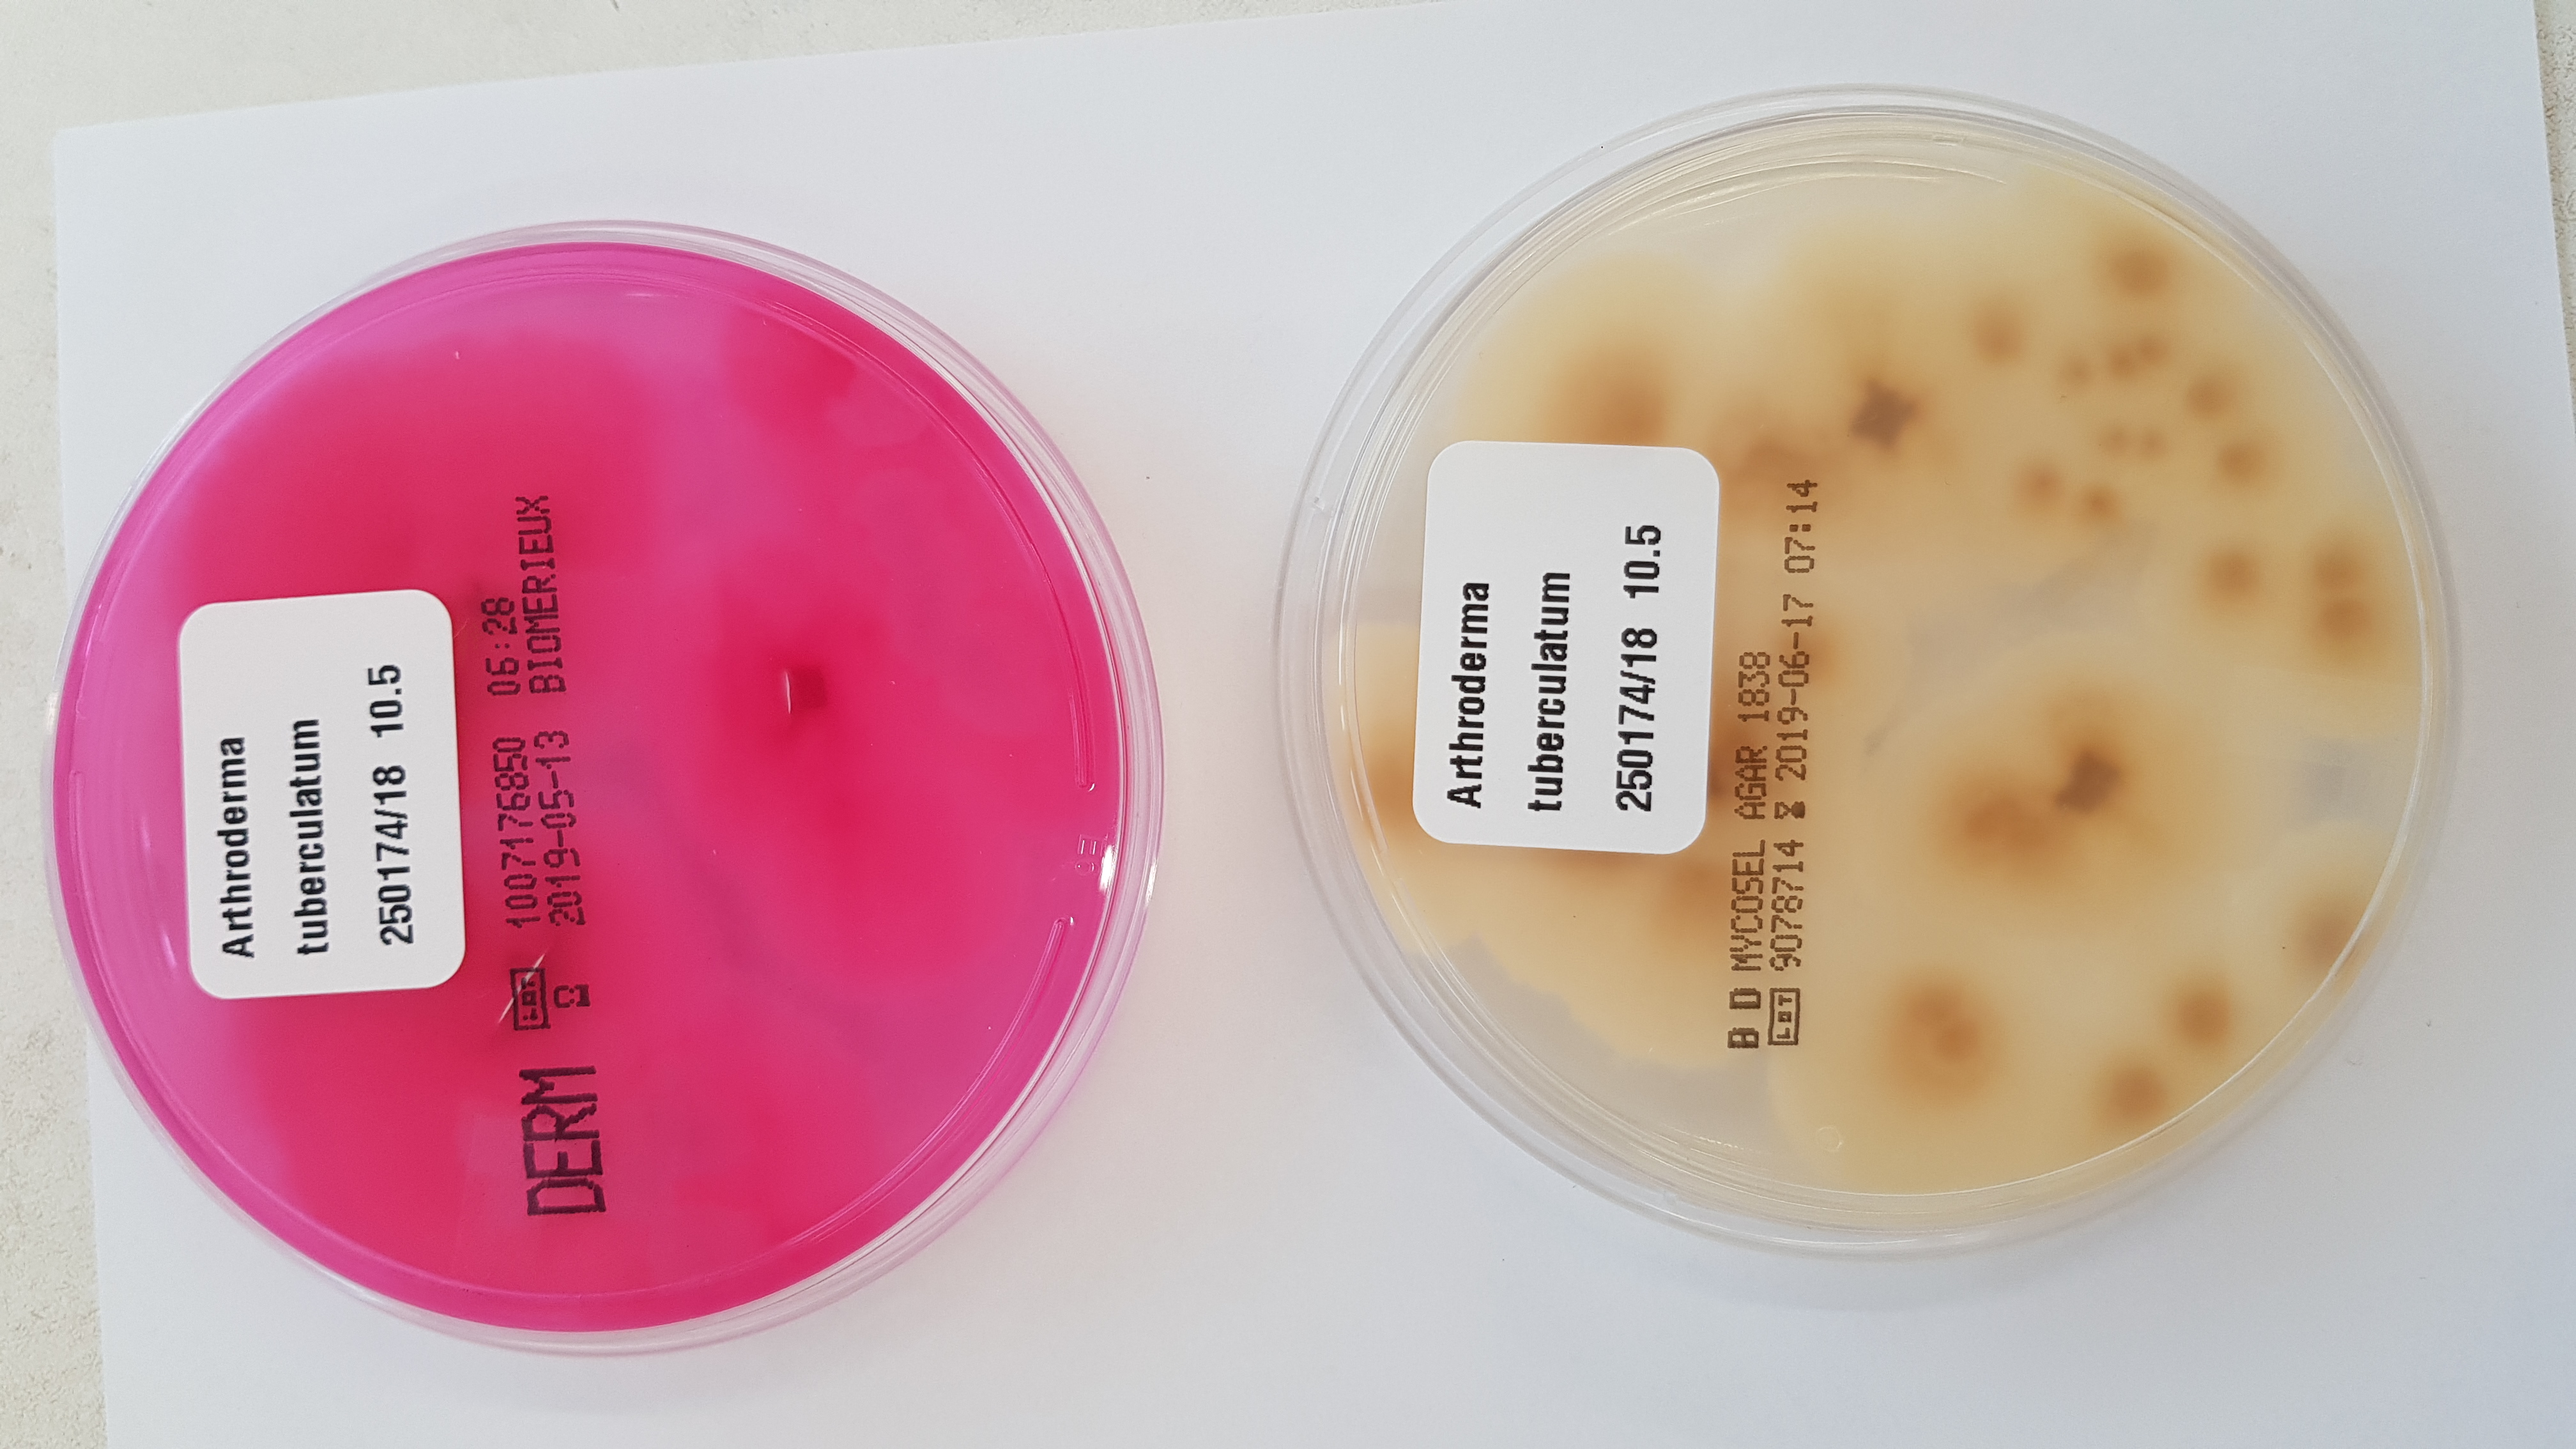
None

Arthroderma tuberculatum Kuehn 1960
Der in der Umwelt ubiquitär im Erdboden vorkommende Pilz Arthroderma (A.) tuberculatum ist ein geophiler Dermatophyt. Taxonomisch wird A. tuberculatum, wie andere Arthroderma-Arten, in die Unterklasse der Eurotiomycetidae und die Klasse Eurotiomycetes eingeordnet. Diese gehören damit letztlich in die Familie Arthrodermataceae der Ordnung der Onygenales.